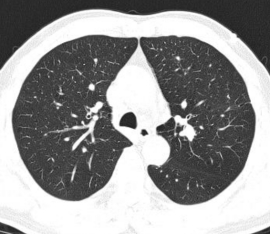

近年来,随着胸部低剂量CT 肺癌筛查的普及,越来越多的肺外周小结节被检出,而这类病灶的精准定性,是肺癌早诊早治的核心关键。但对于位于肺野外周、亚段及以远支气管的微小病灶,传统普通支气管镜难以抵达病灶位置,无法获取足量合格的病理组织,成为临床诊疗的一大难点。近日,重庆医科大学附属大学城医院呼吸与危重症医学科尹小波副主任医师团队,成功为一名左肺固有上叶尖后段外周小结节患者实施超声支气管镜引导下精准活检术,突破普通支气管镜的诊疗局限,微创、高效地明确了病灶病理诊断,为患者后续治疗方案的制定提供了金标准依据。
患者因体检发现左肺结节就诊,胸部CT提示左肺固有上叶尖后段存在微小病灶,病灶位于肺野外周,远离中央气道,普通支气管镜无法直视及抵达病灶,常规活检手段阳性率极低,难以明确病理性质。

图1 术前胸部 CT 肺窗,提示左肺固有上叶尖后段外周小结节病灶
图2 术前胸部 CT 纵隔窗,清晰显示病灶解剖位置,位于中央气道以远的外周肺组织
为精准、微创地明确病灶性质,尹小波副主任医师团队经过充分评估,决定为患者实施径向超声支气管镜(RP-EBUS)引导下经支气管肺活检术。术中,团队通过患者自然气道,将带鞘管的径向超声探头精准送入左肺固有上叶尖后段,沿支气管走向逐步探查,通过超声实时扫描,成功定位到外周的微小病灶,清晰显示病灶的边界、范围及与周围组织的关系,确认活检靶点后,固定鞘管、撤出超声探头,通过工作鞘管精准置入活检钳,对病灶进行多点活检,成功获取足量合格的病变组织。
术后标本送病理科检测,病理结果明确提示:<左固有上叶尖后段> 鳞状细胞癌;免疫组化结果显示 P40 (+)、P63 (+)、CK5/6 (+)(肺鳞状细胞癌特征性标志物阳性),TTF1 (-)、NapsinA (-)(肺腺癌标志物阴性),KI67 约 70%(+),进一步明确了病理分型与增殖活性,为患者后续个体化治疗方案的制定提供了确凿的病理依据。


图3 术中径向超声支气管镜实时成像图,精准定位病灶,清晰显示病灶范围与边界
图4 活检组织 HE 染色病理切片,镜下可见异型鳞状细胞,符合鳞状细胞癌形态特征

图5 最终病理与免疫组化诊断报告,明确病灶为肺鳞状细胞癌
据尹小波副主任医师介绍,传统普通支气管镜仅能观察到段及以上的中央气道,对于位于亚段、亚亚段以远的肺外周微小病灶,既无法直视,也难以精准定位,盲检的诊断阳性率不足30%,对于直径<2cm 的外周小结节,阳性率更低。临床中很多此类患者,不得不接受经胸壁肺穿刺活检,甚至胸腔镜/开胸手术活检,不仅创伤大、风险高,还可能出现气胸、出血等并发症,给患者带来额外的身体负担与心理压力。
而径向超声支气管镜技术,是呼吸介入领域的核心精准诊疗技术,完美填补了普通支气管镜在肺外周病变诊疗中的空白。它通过超细的径向超声探头,可深入到外周细小支气管,通过实时超声成像,“看见”普通支气管镜无法观察到的肺外周病灶,实现毫米级精准定位;配合引导鞘管,可实现对病灶的稳定、多点活检,大幅提升肺外周微小病灶的诊断阳性率,对于直径<2cm 的肺外周结节,诊断阳性率可提升至70%以上。同时,该技术经人体自然气道操作,无体表创口,属于完全微创的诊疗手段,术中出血、气胸等并发症发生率极低,患者术后恢复快,真正实现了 “微创、精准、安全、高效”的诊疗目标。
重庆医科大学附属大学城医院呼吸与危重症医学科,是集医疗、教学、科研于一体的临床重点专科,科室呼吸介入诊疗团队在尹小波副主任医师的带领下,常规开展包括超声支气管镜(径向/凸面)引导下活检术、支气管镜下热消融术、冷冻治疗、气道支架置入术、内科胸腔镜等各类先进呼吸介入诊疗技术,在肺结节精准诊疗、肺部肿瘤微创诊疗、气道病变介入治疗、危重症气道管理等领域具备雄厚的技术实力。科室始终以患者为中心,不断精进诊疗技术,为渝西地区广大肺部疾病患者提供高质量、同质化的精准诊疗服务。
本例超声支气管镜引导下肺外周小结节精准活检术的成功开展,再次印证了科室在肺结节微创精准诊疗领域的技术能力,也为更多肺外周小结节患者提供了一种创伤更小、安全性更高、诊断率更优的确诊方案,助力肺癌的早发现、早诊断、早治疗,为患者的生命健康保驾护航。
撰稿:尹小波
核稿:江宇 胡子牧
审稿:唐博